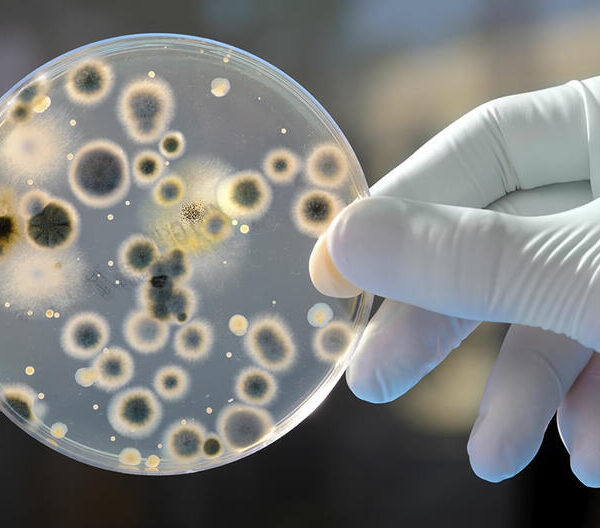

À propos
LA2E a été mandaté par un centre hospitalier pour effectuer l’étalonnage et la vérification annuelle de ses équipements de mesure : balances de laboratoire, thermomètres, étuves et pipettes automatiques. Ce projet a permis de garantir la fiabilité des mesures utilisées pour les diagnostics médicaux et d’aligner les procédures de contrôle interne sur les exigences normatives en vigueur. Un certificat d’étalonnage a été délivré pour chaque instrument vérifié.
ClientEntreprise
Date27 June 2019
SkillsContrôle de précision des instruments biomédicaux

No comment